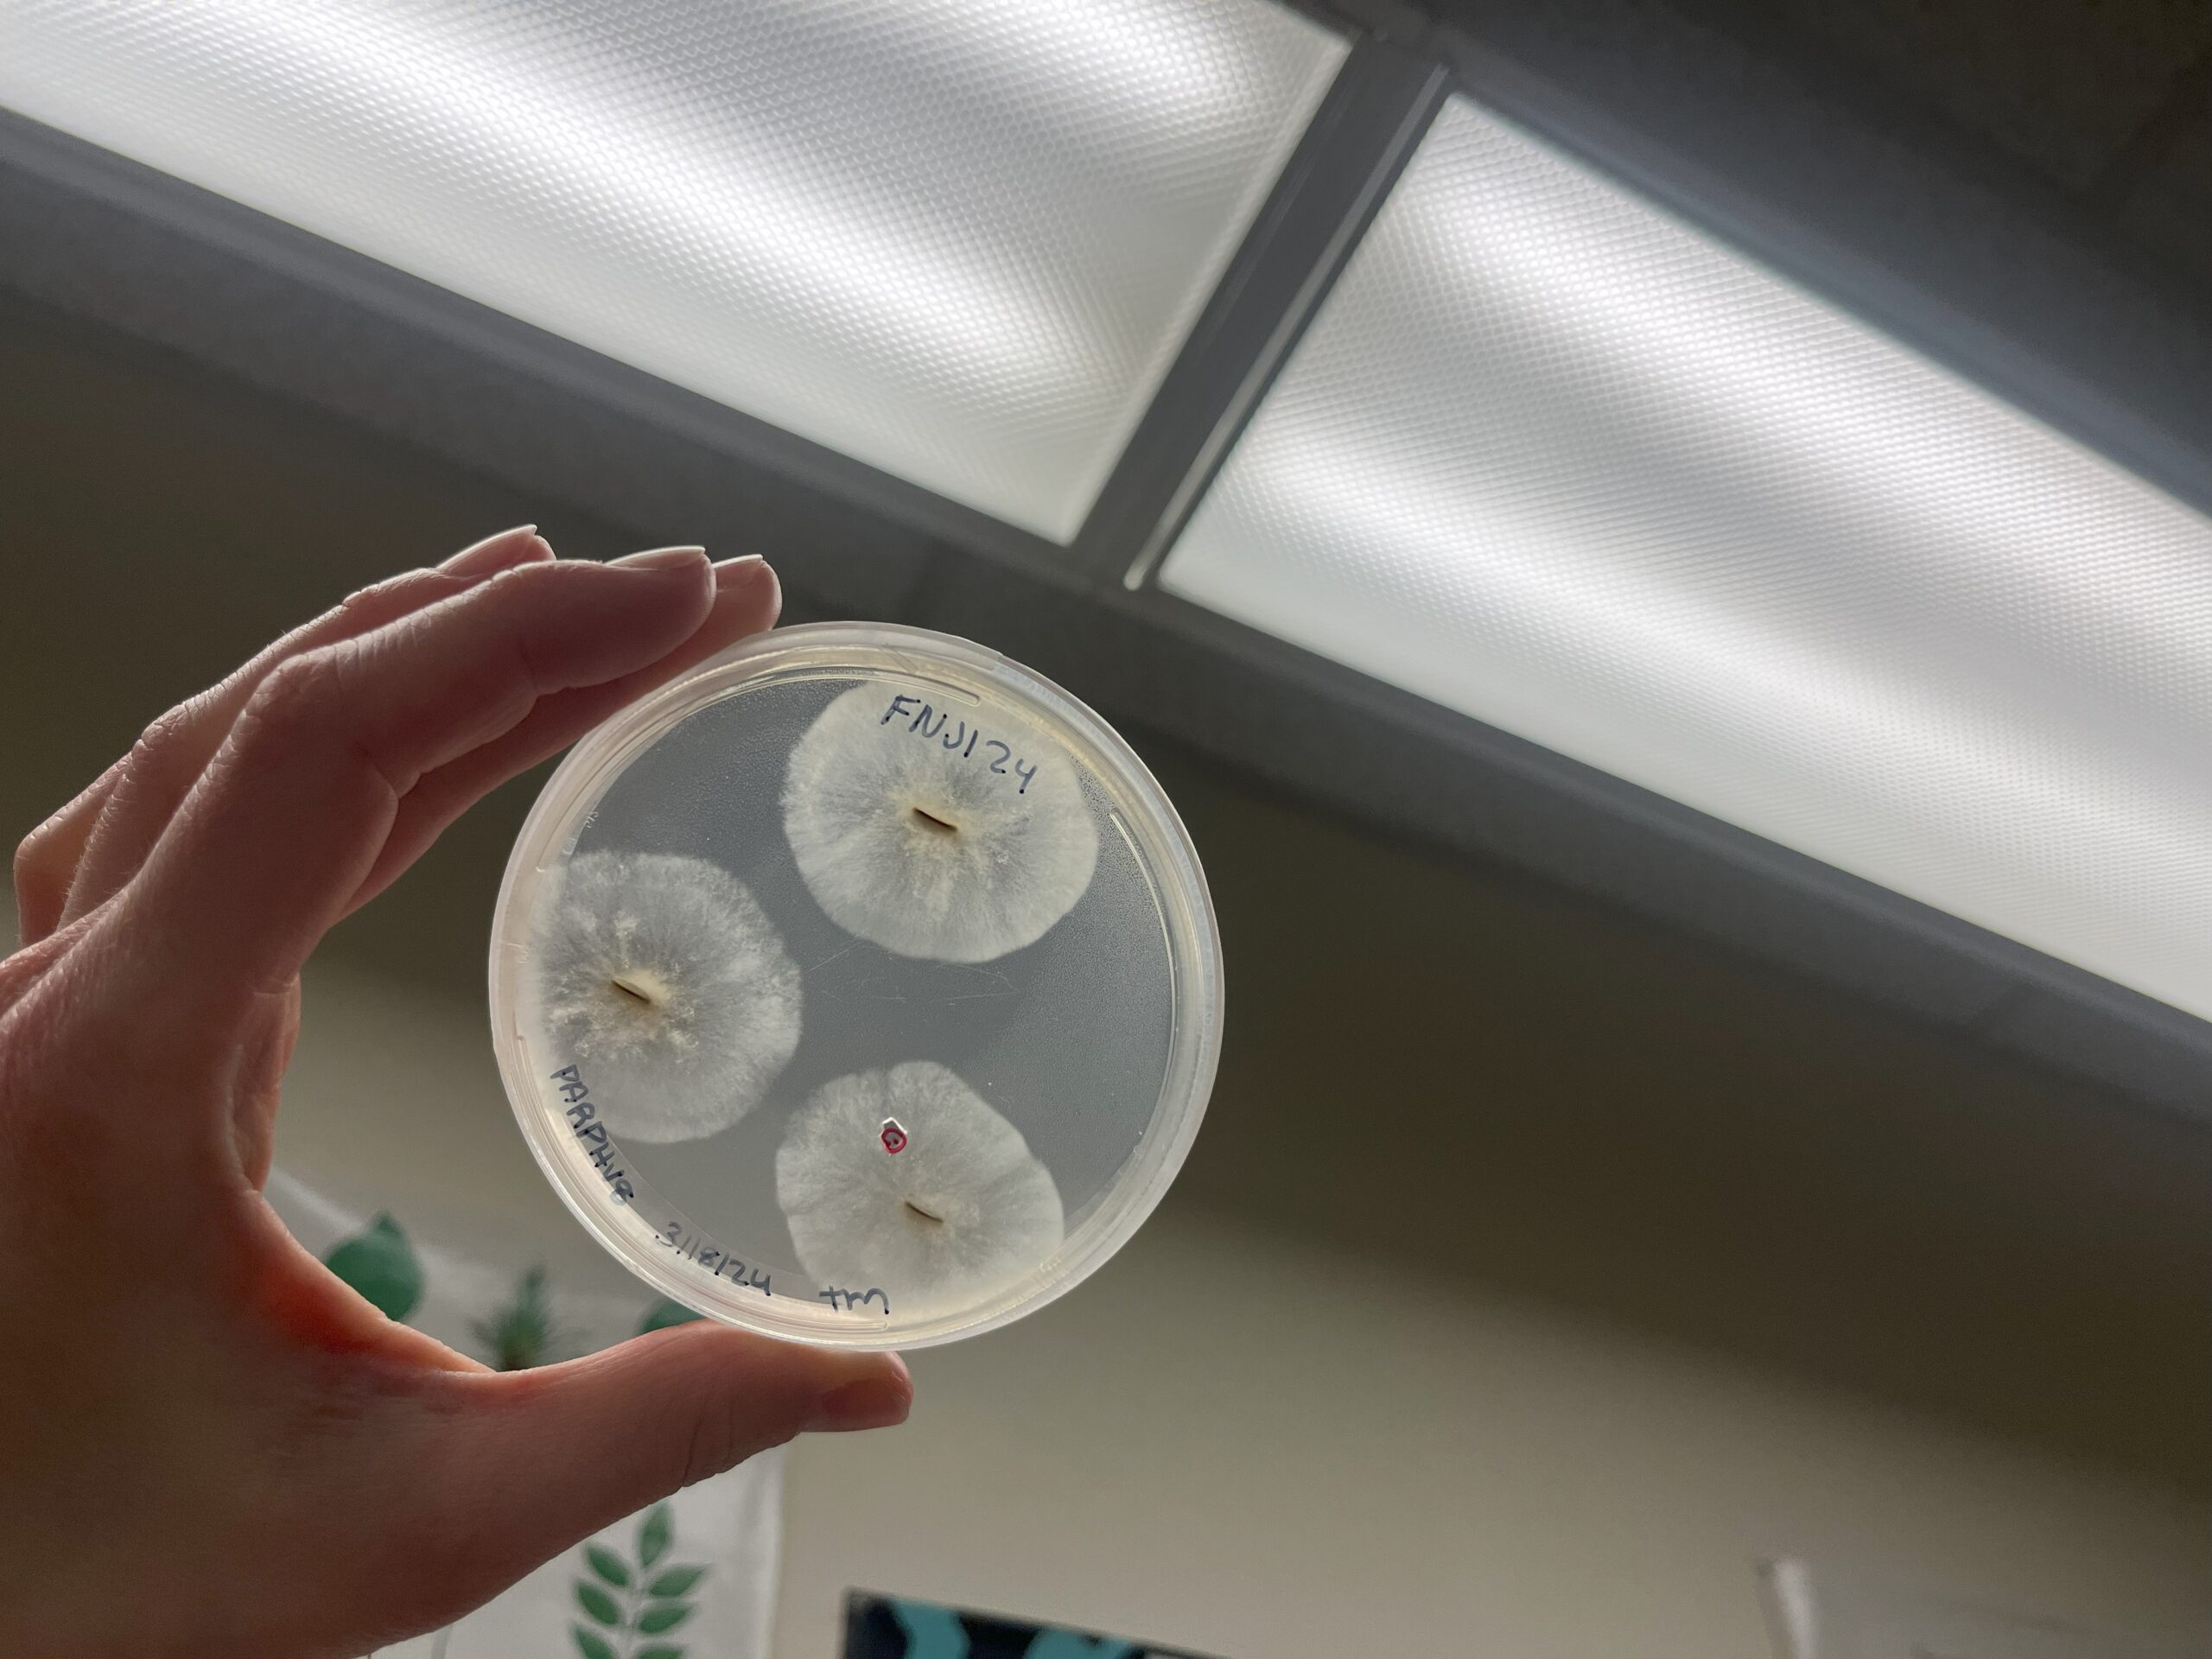
Plate showing potential Oomycetes growing. Image from F. Dewitz

Western Sword Fern Dieback Research
Western Sword Fern (Polystichum munitum)
Western sword ferns (Polystichum munitum) are distributed from southeast Alaska to the central coast of California. Sword ferns are an integral component in the understory of Pacific Northwest (PNW) forests, holding cultural, ecological, and economic value.


The Problem: Sword Fern Dieback
Recent observations indicate sword fern plants are dying in localized areas, particularly in the Puget Sound region. In 2013, reports from Seward Park in Seattle highlighted a concerning decline in fern populations, with areas that previously supported healthy ferns exhibiting extensive dieback.

Fern Dieback Symptoms
The symptoms of sword fern dieback include foliar browning and crisping of the fronds until eventually all that is left is a stump. Fiddle heads may emerge from some stumps the following season, but they may be dwarfed or start browning or crisping soon after.



The Approach
Observations of unhealthy sword ferns recorded on iNaturalist were visited for soil sample collection. At each location, soil samples were collected from three nearby ferns. Symptomatic ferns and some healthy ferns were sampled.

Soil Sampling
The fern that was selected had the leaf litter and duff removed on the top of the soil before collecting the soil. Soil was collected from 3-4 spots around the fern within a meter of the base. About 500 grams of soil and small roots were collected and placed in a plastic bag.
Sampling equipment was sterilized before collecting each sample. Soapy water and a brush were used to clean the soil particles from the sampling shovels. The residual soap was removed by sticking the shovel into the soil near but not in the spot that the next fern was going to be collected.
Searching for Plant Pathogens



Oomycetes
Oomycetes are a class of microbes that can many plant diseases worldwide. The group includes genera such as as Phytophthora and Pythium, which can spread through the movement of infected plants, water, and soil. Commonly referred to as ‘water molds’ these microbes can grow as webs of hyphae or by producing motile zoospores that can swim through water and moist soil. Restoration plantings have linked to the spread of Phytophthora species in some cases.
Soil Baiting
Soil and fine roots were baited for Oomycetes. Each soil sample was placed into a bin and flooded with water. Rhododendron leaves were then added to the flooded soil as ‘baits’. If oomycetes were present in the water, swimming spores would infect the floating bait leaves. After some time, the rhododendron leaves are removed, washed, and incubated before isolation with selective agar is completed.
Get Involved
If you would like to be involved, please let us know with the form below.
Sword Fern Soil Sampling
Please share your details below if you are interested in helping advance knowledge about the dieback of sword ferns in the Pacific Northwest.Collect Soil Samples
If you want to collect soil samples, join the iNaturalist project called ‘Sword Fern Health Watch,’ add observations of unhealthy ferns, and take soil samples!
Soil Sample Collection Guide

